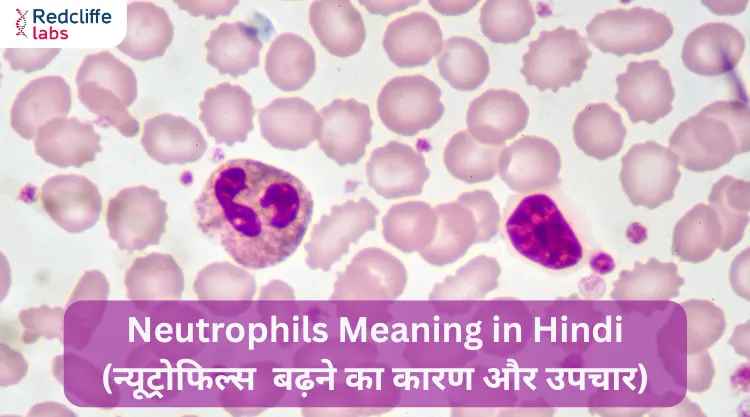
https://myhealth-redcliffelabs.redcliffelabs.com/media/blogcard-images/None/6f61a7b3-eed8-44aa-8345-153e00e4ad34.webp

Neutrophils Meaning in Hindi (न्यूट्रोफिल्स बढ़ने का कारण और उपचार)

Medically Reviewed By
Dr. Mayanka Lodha Seth
Written By Komal Daryani
on Oct 7, 2025
Last Edit Made By Komal Daryani
on Oct 8, 2025
हमारा शरीर एक जटिल प्रणाली है जिसमें अनेक कोशिकाएं एक साथ मिलकर हमें बीमारियों से बचाने का काम करती हैं। ऐसी ही एक महत्वपूर्ण भूमिका निभाती हैं न्यूट्रोफिल्स (Neutrophils), जो सफेद रक्त कोशिकाओं (White Blood Cells) का हिस्सा होती हैं।
न्यूट्रोफिल्स हमारे शरीर की पहली सुरक्षा पंक्ति होते हैं जो किसी भी इन्फेक्शन से लड़ने का काम करते हैं। लेकिन जब ये जरूरत से ज्यादा बढ़ जाते हैं, तो यह किसी रोग, संक्रमण या अन्य स्वास्थ्य समस्याओं का संकेत हो सकता है। इस ब्लॉग में हम विस्तार से समझेंगे।
न्यूट्रोफिल क्या हैं और ये कैसे काम करते हैं?
न्यूट्रोफिल, श्वेत रक्त कोशिकाओं (ल्यूकोसाइट्स) का एक प्रकार है, जो शरीर की इम्यून सिस्टम की पहली रक्षा पंक्ति के रूप में काम करता है।
श्वेत रक्त कोशिकाएं मुख्य रूप से तीन प्रकार की होती हैं:
- ग्रेन्यूलोसाइट्स
- लिम्फोसाइट्स
- मोनोसाइट्स
न्यूट्रोफिल, ग्रेन्यूलोसाइट्स की श्रेणी में आते हैं और ये इओसिनोफिल और बेसोफिल के साथ मिलकर इस समूह का हिस्सा बनाते हैं। ये सभी कोशिकाएं मिलकर शरीर को संक्रमण, बैक्टीरिया और चोट से बचाने का काम करती हैं।
न्यूट्रोफिल्स का सामान्य स्तर क्या होता है?
सामान्य रूप से, ब्लड टेस्ट में न्यूट्रोफिल्स की संख्या इस प्रकार होती है:
कुल WBC का 55-70% हिस्सा न्यूट्रोफिल्स होते हैं
वयस्कों में न्यूट्रोफिल्स की सामान्य रेंज होती है:
2,500 से 7,500 प्रति माइक्रोलिटर (µL) रक्त
यदि न्यूट्रोफिल्स की संख्या 7,500 से ऊपर हो जाए, तो इसे न्यूट्रोफिलिया (Neutrophilia) कहा जाता है, यानी शरीर में न्यूट्रोफिल्स का असामान्य रूप से बढ़ना।
न्यूट्रोफिल्स बढ़ने के कारण
न्यूट्रोफिल्स का बढ़ना शरीर में गंभीर स्थिति की ओर इशारा करता है। इसके पीछे कई कारण हो सकते हैं:
1. बैक्टीरियल संक्रमण (Bacterial Infection)
जब शरीर में बैक्टीरिया से संक्रमण होता है, जैसे फेफड़ों का संक्रमण, यूरिनरी ट्रैक्ट इन्फेक्शन, टॉन्सिलाइटिस—तो न्यूट्रोफिल्स की संख्या बढ़ जाती है।
2. सूजन या चोट (Inflammation or Injury)
किसी भी आंतरिक या बाहरी चोट, कट, जलन या ऑपरेशन के बाद भी शरीर में सूजन के कारण न्यूट्रोफिल्स का स्तर बढ़ सकता है।
3. तनाव (Physical or Emotional Stress)
अत्यधिक मानसिक या शारीरिक तनाव में भी अस्थायी रूप से न्यूट्रोफिल्स की संख्या बढ़ जाती है।
4. धूम्रपान और प्रदूषण
लंबे समय तक धूम्रपान करने या अत्यधिक वायु प्रदूषण में रहने से शरीर में सूजन की स्थिति बनती है, जिससे न्यूट्रोफिल्स का स्तर ऊँचा हो सकता है।
5. दवाओं का प्रभाव
कुछ स्टेरॉयड, लिथियम या अन्य दवाएं न्यूट्रोफिल्स की संख्या बढ़ा सकती हैं।
6. ब्लड कैंसर और बोन मैरो संबंधी रोग
ल्यूकेमिया या अन्य रक्त विकारों में शरीर अत्यधिक मात्रा में न्यूट्रोफिल्स बनाना शुरू कर देता है।
7. ऑपरेशन या ट्रॉमा
किसी बड़ी सर्जरी, दुर्घटना या जलने की स्थिति में भी न्यूट्रोफिल्स बढ़ सकते हैं।
न्यूट्रोफिल काउंट असामान्य होने पर क्या हो सकता है?
अगर आपके शरीर में न्यूट्रोफिल की संख्या 1,500 प्रति माइक्रोलीटर से कम हो जाती है, तो संक्रमण का खतरा बढ़ जाता है। न्यूट्रोफिल की बहुत कम संख्या (न्यूट्रोपेनिया) गंभीर स्थिति बन सकती है, जिसमें रोगी को सामान्य संक्रमण भी जानलेवा बन सकता है।
वहीं, अगर न्यूट्रोफिल काउंट बहुत ज्यादा है, तो यह संकेत हो सकता है कि शरीर किसी संक्रमण से लड़ रहा है, या आप अत्यधिक तनाव में हैं। कई बार यह किसी गंभीर बीमारी या अंदरूनी समस्या का लक्षण भी हो सकता है।
न्यूट्रोपेनिया दो प्रकार का होता है:
कुछ मामलों में यह अस्थायी होता है और जल्दी ठीक हो जाता है। वहीं, कुछ मामलों में यह लंबे समय तक बना रहता है, जिससे रोग प्रतिरोधक क्षमता कमजोर हो जाती है और लगातार संक्रमण का खतरा बना रहता है।
यदि न्यूट्रोफिल का असंतुलन किसी और बीमारी की वजह से हो रहा है, तो सही निदान और इलाज के लिए तुरंत किसी इंटरनल मेडिसिन स्पेशलिस्ट से संपर्क करें।
न्यूट्रोफिल्स बढ़ने के लक्षण
कई बार न्यूट्रोफिल्स बढ़ने के कोई विशेष लक्षण नहीं होते, लेकिन नीचे दिए गए संकेत इस स्थिति की ओर इशारा कर सकते हैं:
- लगातार बुखार रहना
- थकान और कमजोरी
- सांस फूलना
- सूजन या लालिमा
- हड्डियों या जोड़ों में दर्द
- बार-बार संक्रमण होना
- शरीर में जलन या खुजली
अगर उपरोक्त लक्षण लंबे समय तक बने रहें, तो डॉक्टर से संपर्क करना आवश्यक है।
न्यूट्रोफिल्स बढ़ने पर कौन-कौन सी बीमारियाँ हो सकती हैं?
न्यूट्रोफिल्स का असामान्य रूप से बढ़ा हुआ स्तर कई बीमारियों की ओर इशारा कर सकता है:
- निमोनिया, टॉन्सिलाइटिस, यूटीआई जैसे बैक्टीरियल संक्रमण
- आंतों की सूजन, जैसे क्रोहन रोग या अल्सरेटिव कोलाइटिस
- गंभीर चोट या जलने की स्थिति
- ब्लड कैंसर या बोन मैरो की असामान्यताएं
- रूमेटॉइड अर्थराइटिस या ल्यूपस जैसी ऑटोइम्यून बीमारियाँ
न्यूट्रोफिल्स को कंट्रोल करने के उपाय
अगर न्यूट्रोफिल्स का स्तर सामान्य से अधिक है, तो घबराएं नहीं। इसके पीछे के कारण की जांच करना और सही इलाज करवाना जरूरी होता है। नीचे कुछ उपाय दिए गए हैं:
मूल कारण का इलाज करें
न्यूट्रोफिल्स का बढ़ना कोई बीमारी नहीं बल्कि किसी बीमारी का लक्षण है। इसलिए पहले यह पता लगाना जरूरी है कि वृद्धि का कारण क्या है, संक्रमण, सूजन, दवा या अन्य कोई रोग।
दवाएं डॉक्टर की सलाह से लें
अगर किसी विशेष दवा से न्यूट्रोफिल्स बढ़े हैं, तो डॉक्टर उस दवा को बदल सकते हैं या उसका डोज कम कर सकते हैं।
संक्रमण से बचाव
साफ-सफाई का ध्यान रखें, मास्क पहनें, भीड़भाड़ से बचें और खानपान में सतर्कता बरतें।
धूम्रपान और शराब से परहेज
धूम्रपान और अल्कोहल शरीर की प्रतिरोधक क्षमता को कमजोर करते हैं और सूजन बढ़ाते हैं। इन्हें पूरी तरह त्यागना बेहतर होता है।
तनाव को करें कम
योग, ध्यान और अच्छी नींद से मानसिक तनाव कम किया जा सकता है, जिससे शरीर की प्रतिरक्षा प्रणाली संतुलित रहती है।
न्यूट्रोफिल्स बढ़ने पर क्या खाएं?
खाने योग्य चीजें:
- हरी पत्तेदार सब्जियां
- मौसमी फल (कम शर्करा वाले)
- हल्दी, अदरक जैसे प्राकृतिक एंटी-इंफ्लेमेटरी पदार्थ
- विटामिन C युक्त आहार (नींबू, आंवला, संतरा)
- दालें, ओट्स, ब्राउन राइस
न्यूट्रोफिल्स हमारे शरीर के सुरक्षा सैनिक हैं, लेकिन जब इनकी संख्या जरूरत से ज्यादा बढ़ जाती है, तो यह किसी गहरी स्वास्थ्य समस्या की चेतावनी हो सकती है। इसलिए सिर्फ रिपोर्ट देखकर घबराने की जरूरत नहीं है, बल्कि इसके पीछे की वजह को समझना और सही इलाज लेना ज़रूरी है।
संतुलित खानपान, साफ-सफाई, तनाव मुक्त जीवन और नियमित जांच से न सिर्फ न्यूट्रोफिल्स का स्तर संतुलित रहता है, बल्कि आपकी इम्यूनिटी भी मजबूत बनी रहती है।



